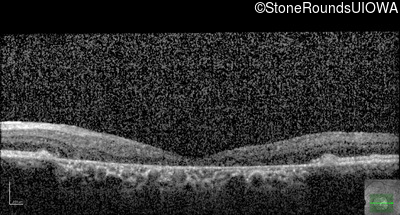
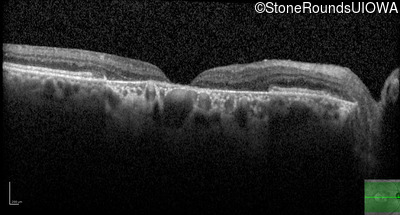
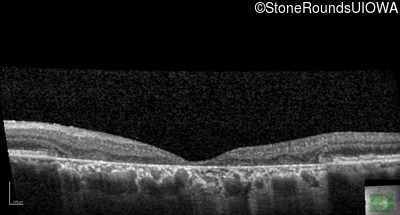

Case
SR3050
Student Mode
Pattern Dystrophy (IIC)
Male
Male
Hidden
SR3050
Student Mode
Pattern Dystrophy (IIC)
Male
Male
History
This 47 year man first experienced some decrease in his central vision about 10 years ago.
| Age at visit: 49 years |
| Age at visit: 55 years |
| OD | OS | ||
|---|---|---|---|
| OD | OS | ||
|---|---|---|---|
| OD | OS | ||
|---|---|---|---|
| Age at visit: 77 years |
Diagnosis & molecular findings
| Disease | Gene | Allele 1 variant(s) | Allele 2 variant(s) | Inheritance mode |
|---|---|---|---|---|
| Pattern Dystrophy | PRPH2 | Gly167Asp GGC>GAC | AD |